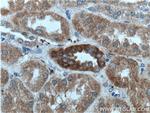
NAGK Antibody in Immunohistochemistry (Paraffin) (IHC (P))
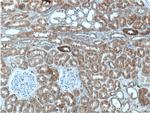
NAGK Antibody in Immunohistochemistry (Paraffin) (IHC (P))

Search
Proteintech
NAGK Polyclonal Antibody
{{$productOrderCtrl.translations['antibody.pdp.commerceCard.promotion.promotions']}}
{{$productOrderCtrl.translations['antibody.pdp.commerceCard.promotion.viewpromo']}}
{{$productOrderCtrl.translations['antibody.pdp.commerceCard.promotion.promocode']}}: {{promo.promoCode}} {{promo.promoTitle}} {{promo.promoDescription}}. {{$productOrderCtrl.translations['antibody.pdp.commerceCard.promotion.learnmore']}}
产品信息
15051-1-AP
种属反应
宿主/亚型
分类
类型
抗原
偶联物
形式
浓度
规格
纯化类型
保存液
内含物
保存条件
运输条件
产品详细信息
Immunogen sequence: MAAIYGGVE GGGTRSEVLL VSEDGKILAE ADGLSTNHWL IGTDKCVERI NEMVNRAKRK AGVDPLVPLR SLGLSLSGGD QEDAGRILIE ELRDRFPYLS ESYLITTDAA GSIATATPDG GVVLISGTGS NCRLINPDGS ESGCGGWGHM MGDEGSAYWI AHQAVKIVFD SIDNLEAAPH DIGYVKQAMF HYFQVPDRLG ILTHLYRDFD KCRFAGFCRK IAEGAQQGDP LSRYIFRKAG EMLGRHIVAV LPEIDPVLFQ GKIGLPILCV GSVWKSWELL KEGFLLALTQ GREIQAQNFF SSFTLMKLRH SSALGGASLG ARHIGHLLPM DYSANAIAFY SYTFS (1-344 aa encoded by BC001029)
靶标信息
SPG20 is a protein containing a MIT (Microtubule Interacting and Trafficking molecule) domain, and is implicated in regulating endosomal trafficking and mitochondria function. The protein localizes to mitochondria and partially co-localizes with microtubules. Stimulation with epidermal growth factor (EGF) results in protein translocation to the plasma membrane, and the protein functions in the degradation and intracellular trafficking of EGF receptor.
仅用于科研。不用于诊断过程。未经明确授权不得转售。
生物信息学
蛋白别名: epididymis secretory sperm binding protein; GlcNAc kinase; Muramyl dipeptide kinase; N-acetyl-D-glucosamine kinase; N-acetyl-D-mannosamine kinase; N-Acetylglucosamine kinase; NAGK; unnamed protein product
基因别名: GNK; HSA242910; NAGK
UniProt ID: (Human) Q9UJ70, (Mouse) Q9QZ08, (Rat) P81799
Entrez Gene ID: (Human) 55577, (Mouse) 56174, (Rat) 297393